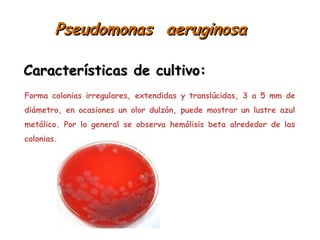
Pseudomonas aeruginosaPseudomonas aeruginosa
Forma colonias irregulares, extendidas y translúcidas, 3 a 5 mm de
diámetro, en ocasiones un olor dulzón, puede mostrar un lustre azul
metálico. Por lo general se observa hemólisis beta alrededor de las
colonias.
Características de cultivo:Características de cultivo:
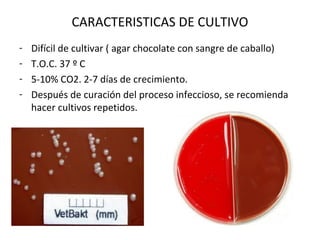
CARACTERISTICAS DE CULTIVO
- Difícil de cultivar ( agar chocolate con sangre de caballo)
- T.O.C. 37 º C
- 5-10% CO2. 2-7 días de crecimiento.
- Después de curación del proceso infeccioso, se recomienda
hacer cultivos repetidos.

Este documento resume las características de cuatro géneros de bacterias Gram negativas: Pseudomonas, Burkholderia, Bordetella y Taylorella. Describe sus hábitats, factores de virulencia, poder patógeno y enfermedades asociadas. Se enfoca en especies importantes como P. aeruginosa, B. pseudomallei, B. bronchiseptica y T. equigenitalis.